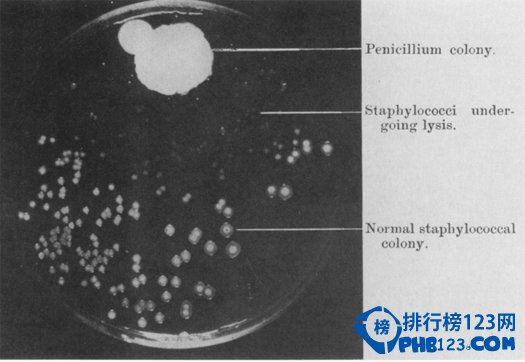

人体解剖(Human Anatomy)

16世纪早期,大部分对人体的认知都源自一个名叫盖伦的古罗马医生。但其实在罗马宗教中,人体解剖是被禁止的,盖伦的人体解剖学更多是根据动物解剖作出的推测。得知这事以后,安德烈亚斯•安德鲁斯就决定开始自己进行遗体解剖,研究人体,并最终发表了一份比以往任何时候都准确得多的人体解剖学说明,还配备了不少插图,比如上图那样。
日心说(Heliocentrism)

哥白尼关于地球不是宇宙中心,太阳才是的发现,在16世纪时是一个极具争议的宣言,对于宗教中地球不动的信仰而言冲击则尤其强烈。尽管地心说并不符合亚里士多德关于所有天体都做匀速圆周运动的假说,人们对日心说的抗拒很可能就是哥白尼的著作《天球运行论》(The Revolution of Heavenly Spheres)直到临终才发表的原因。这张图上,画的就是哥白尼的日心太阳系模型。
天花疫苗(Smallpox Vaccine)

当爱德华•詹纳发现,长过过牛痘这种相当无害的病的挤奶女工们,没有天花感染的相关记录时,他开始思考这件事情。在那时候,接种天花疫苗的唯一办法是比较少量地用病毒本身进行接种,但这并不总是安全的,有时候甚至会导致死亡。1796年,利用一位年轻女工手上的牛痘病灶样本,詹纳为一位8岁男孩进行了接种。男孩生了一场小病,但在10天之后就痊愈了。几周以后,他又为男孩注射了天花,事实证明他是对的,男孩没有出现天花的任何病征。这张图画的就是一个挤奶女工长了牛痘的手。
天花在20世纪70年代被彻底消灭。
微生物的发现(Discovery of Microorganisms)

17世纪,安东•冯•列文虎克制造了超过500个“显微镜”,这张图就是其中一些的图样。它们不是我们现在用的复合式显微镜,而是一些高放大率的放大镜。通过这些显微镜,他观察了湖水水样,发现并描述了存在于水中的微生物,包括一些藻类。后来他还观察了很多别的微生物。
336c.com
有丝分裂的证实(Identification of Mitosis)

通过在染色玻片上比较活细胞,瓦尔特•弗莱明确了有丝分裂的阶段和先后顺序。他利用当时新发明的苯胺染料,标识出了被测细胞中一种线状的物质,这种物质随后被命名为染色体。此图显示了弗莱明在人类角膜组织中观察到的细胞分裂。
排行榜,品牌排行榜
染色体遗传(Role Of The Chromosome In Heredity)

托马斯•亨特•摩根注意到他的果蝇群中出现了一个稀有的性状:白眼。他把这只果蝇和其它红眼果蝇一起饲养。由此产生的子代的眼睛全是红色的,但第二代杂交产生的那些白眼果蝇,全都是雄性的。于是,他假定该性状基因是在X染色体上,并且提出他的伴性遗传理论。这张实验说明图于1914年在《流行科学》杂志上刊登。
第一张照片(The First Photograph)

19世纪初,尼埃普斯•涅普斯用一种被命名为感光制版法的方法,制作出了世界上第一张照片,就是上图这张。在当时,他认为平板印刷技术还不够完善,于是换而使用一个相机暗室和涂满某种沥青的锡板,这种沥青在光照下会硬化,从而把看到的画面永远的固定下来。
物竞天择(Natural Selection)
copyright 336c.com

或许关于“这是神马原理”的思考,最有名的例子就是查尔斯•达尔文的自然选择理论了。他在小猎犬号船上航行的五年时间,使他得以研究世界各地的野生动物,其中在加拉帕戈斯群岛上观察到的山雀喙的变种,具有里程碑式的意义(如图所示)。与一般看法相反,达尔文在岛上时还没有开始考虑这个问题的。而后,他花了很多年工作从而提出他的理论。
板块漂移(Continental Drift)

有时候,“神马原理”的思考可能仅仅因为从一个新角度去审视普通的东西。阿尔弗莱德•魏格纳就是这样一个例子。他注意到,南美洲的东海岸线和非洲的西海岸线能像拼图一样拼在一起。尽管不是第一个发现的,他开始拼合这些地图,并发现不同大陆对应地区的地理特性也十分相似,比如北美阿巴拉契亚山脉对应于苏格兰高地。他以此为证,提出了板块漂移学说。这一学说认为,现在的各大陆板块,都是从某块单一的古大陆分离开来的。上图来自于魏格纳的著作《大陆和海洋的形成》,显示了这整个分离过程的不同阶段。在他发表他的理论后,很多科学家几乎立刻同声一致地反对。几十年以后,很多其它科学家的研究成果越来越多的支持这一理论,他的理论才最终被接受。
发现青霉素(Discovery of Penicillin)
336c.com
1928年,亚历山大•弗莱明(Alexander Flaming)注意到,不小心被霉菌污染的金黄色葡萄球菌培养基上,霉菌周围并没有细菌生长,就像图示那样。进一步的实验表明,即使稀释8倍,霉菌依然有良好的抗菌性。他将这种来自于点青霉菌的化合物命名为“青霉素”。他因此与两位曾在二战期间对青霉素研究作出杰出贡献的科学家,霍华德•弗洛里(Howard Florey)和恩斯特•钱恩(Ernsn Chain),共享了诺贝尔医学奖。